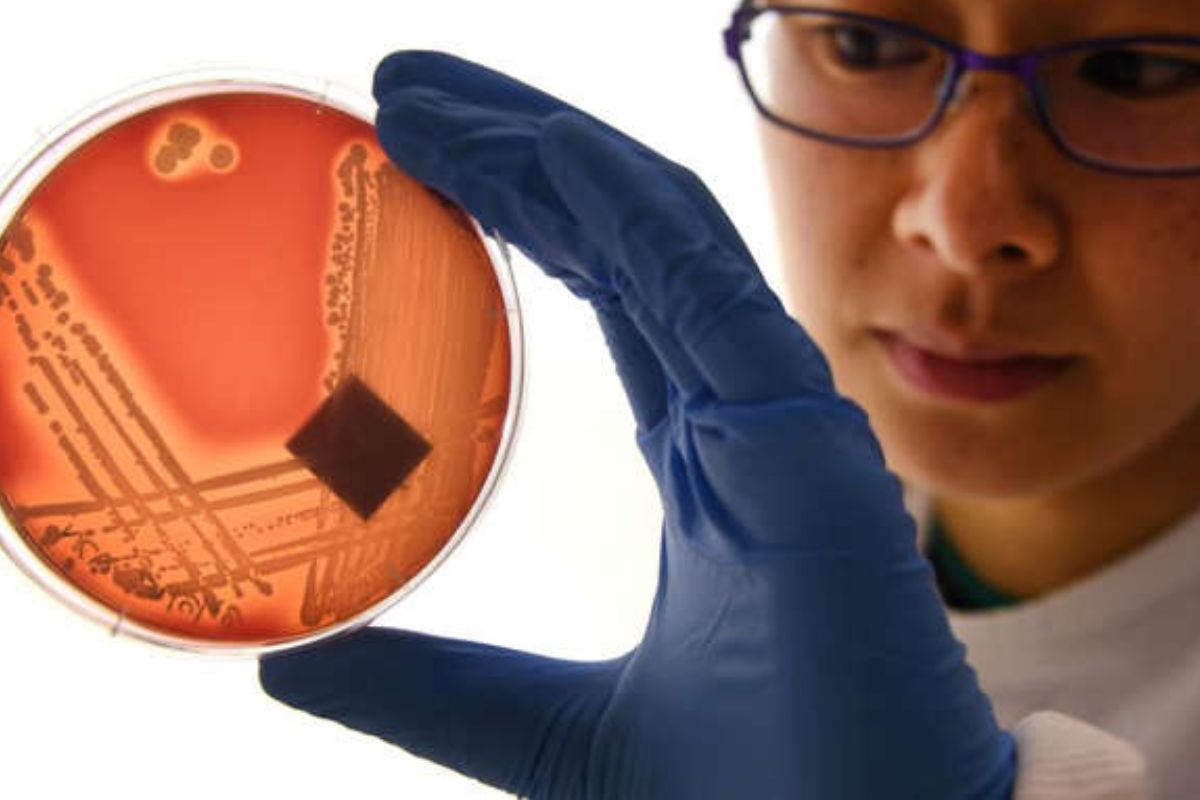
Un estudio financiado por el gobierno del Reino Unido muestra que si las autoridades no actúan para combatir la amenaza de las superbacterias ©The Daily Digest

Las superbacterias podrían matar más que el cáncer en 2050- una nueva advertencia mundial llega desde el Reino Unido pues si no se toman medidas urgentes, las infecciones resistentes a los antibióticos podrían convertirse en la principal causa de muerte en el mundo.
Una amenaza creciente
Un informe financiado por el gobierno británico y difundido por The Guardian revela que la resistencia antimicrobiana (RAM) podría provocar hasta 10 millones de muertes anuales para 2050. Esto superaría las cifras actuales del cáncer, convirtiendo a las superbacterias en la principal amenaza sanitaria del siglo XXI.
¿Qué son las superbacterias?
Las superbacterias son microorganismos que han desarrollado resistencia a múltiples antibióticos, lo que las hace difíciles —y a veces imposibles— de tratar. Esta resistencia suele surgir por el uso excesivo o incorrecto de antibióticos, tanto en humanos como en animales.
Un escenario peor del previsto
El estudio advierte que, sin políticas efectivas, el panorama podría ser mucho más grave de lo estimado en informes anteriores. La situación se agrava en países con acceso desigual a medicamentos o con infraestructuras sanitarias colapsadas.
Te puede interesar- Cada año nacen 74.000 bebés con hepatitis C en el mundo
¿Cómo frenar esta crisis?
Las recomendaciones incluyen:
- Reducción del uso innecesario de antibióticos en medicina y agricultura.
- Inversión en investigación de nuevos fármacos.
- Campañas de concientización global sobre la RAM.
Pero la gran pregunta es: ¿los gobiernos actuarán a tiempo o esperarán a que sea demasiado tarde?, si no se toman decisiones urgentes, podríamos estar frente a una era post-antibiótica, donde infecciones comunes como una neumonía o una herida mal curada vuelvan a ser mortales. Y lo más alarmante: el reloj ya está corriendo.
Ejemplos de superbacterias peligrosas
- MRSA (Staphylococcus aureus resistente a la meticilina)- provoca infecciones en la piel, pulmones y en el torrente sanguíneo. Es común en hospitales y puede volverse letal si no se trata a tiempo.
- Klebsiella pneumoniae- puede causar neumonía, infecciones urinarias y septicemia. Algunas cepas son resistentes a los carbapenémicos, antibióticos de “último recurso”.
- Escherichia coli (E. coli) resistente- esta bacteria intestinal puede generar infecciones urinarias graves y otras infecciones sistémicas. Algunas variantes son casi intratables.
- Acinetobacter baumannii- común en unidades de cuidados intensivos. Es resistente a múltiples antibióticos y puede sobrevivir en superficies por largos períodos.
- Enterococcus resistente a la vancomicina (VRE)- infecta heridas, el tracto urinario y el flujo sanguíneo. La vancomicina solía ser la última línea de defensa.
Global
